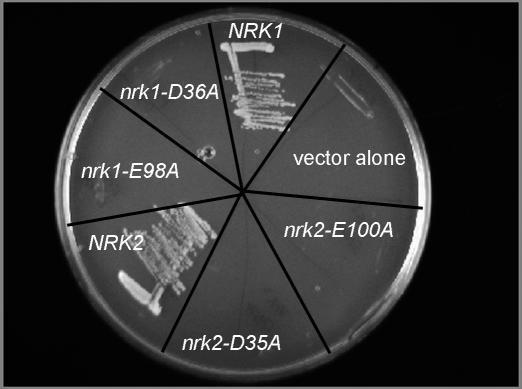
https://cdn.ncbi.nlm.nih.gov/pmc/blobs/9a69/2043028/59ee3b4436cd/pbio.0050263.g003.jpg
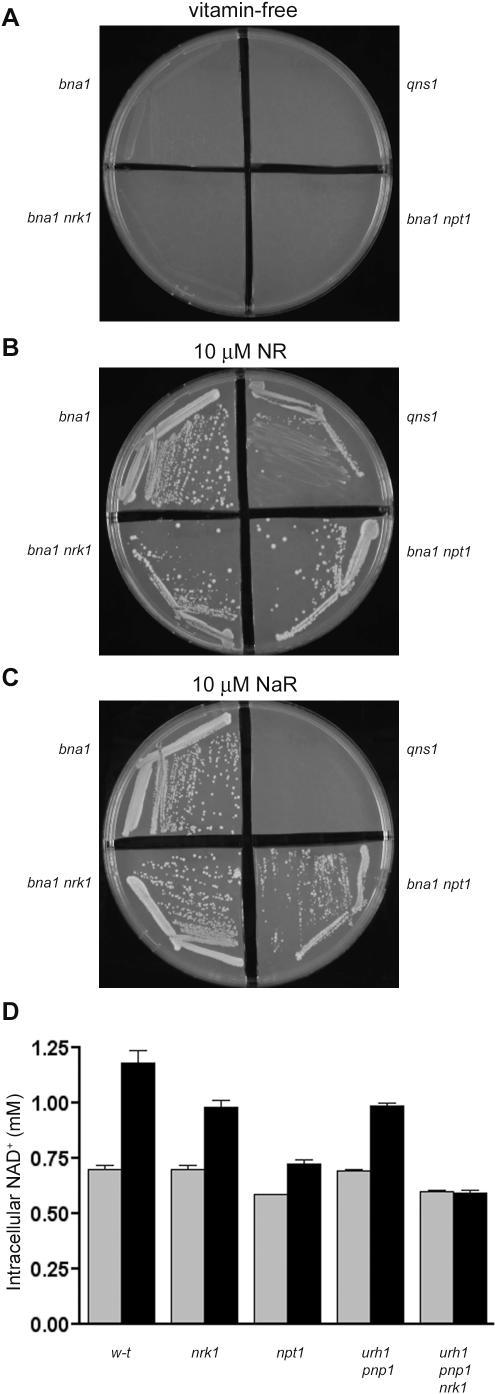
https://cdn.ncbi.nlm.nih.gov/pmc/blobs/9a69/2043028/6b6157da55b5/pbio.0050263.g006.jpg

烟酰胺核糖激酶结构揭示了通往烟酰胺腺嘌呤二核苷酸(NAD⁺)的新途径。
Nicotinamide riboside kinase structures reveal new pathways to NAD+.
作者信息
Tempel Wolfram, Rabeh Wael M, Bogan Katrina L, Belenky Peter, Wojcik Marzena, Seidle Heather F, Nedyalkova Lyudmila, Yang Tianle, Sauve Anthony A, Park Hee-Won, Brenner Charles
机构信息
Structural Genomics Consortium and Department of Pharmacology, University of Toronto, Toronto, Canada.
出版信息
PLoS Biol. 2007 Oct 2;5(10):e263. doi: 10.1371/journal.pbio.0050263.
The eukaryotic nicotinamide riboside kinase (Nrk) pathway, which is induced in response to nerve damage and promotes replicative life span in yeast, converts nicotinamide riboside to nicotinamide adenine dinucleotide (NAD+) by phosphorylation and adenylylation. Crystal structures of human Nrk1 bound to nucleoside and nucleotide substrates and products revealed an enzyme structurally similar to Rossmann fold metabolite kinases and allowed the identification of active site residues, which were shown to be essential for human Nrk1 and Nrk2 activity in vivo. Although the structures account for the 500-fold discrimination between nicotinamide riboside and pyrimidine nucleosides, no enzyme feature was identified to recognize the distinctive carboxamide group of nicotinamide riboside. Indeed, nicotinic acid riboside is a specific substrate of human Nrk enzymes and is utilized in yeast in a novel biosynthetic pathway that depends on Nrk and NAD+ synthetase. Additionally, nicotinic acid riboside is utilized in vivo by Urh1, Pnp1, and Preiss-Handler salvage. Thus, crystal structures of Nrk1 led to the identification of new pathways to NAD+.
真核生物烟酰胺核糖激酶(Nrk)途径在神经损伤时被诱导,可促进酵母的复制寿命,该途径通过磷酸化和腺苷酸化将烟酰胺核糖转化为烟酰胺腺嘌呤二核苷酸(NAD+)。人Nrk1与核苷、核苷酸底物及产物结合的晶体结构显示,该酶在结构上与Rossmann折叠代谢物激酶相似,并确定了活性位点残基,这些残基在体内对人Nrk1和Nrk2的活性至关重要。尽管这些结构解释了烟酰胺核糖与嘧啶核苷之间500倍的差异,但未发现能识别烟酰胺核糖独特羧酰胺基团的酶特征。实际上,烟酸核糖是人Nrk酶的特异性底物,在酵母中可通过一种依赖于Nrk和NAD+合成酶的新型生物合成途径被利用。此外,烟酸核糖在体内可被Urh1、Pnp1和普赖斯-汉德勒补救途径利用。因此,Nrk1的晶体结构促成了新的NAD+合成途径的发现。